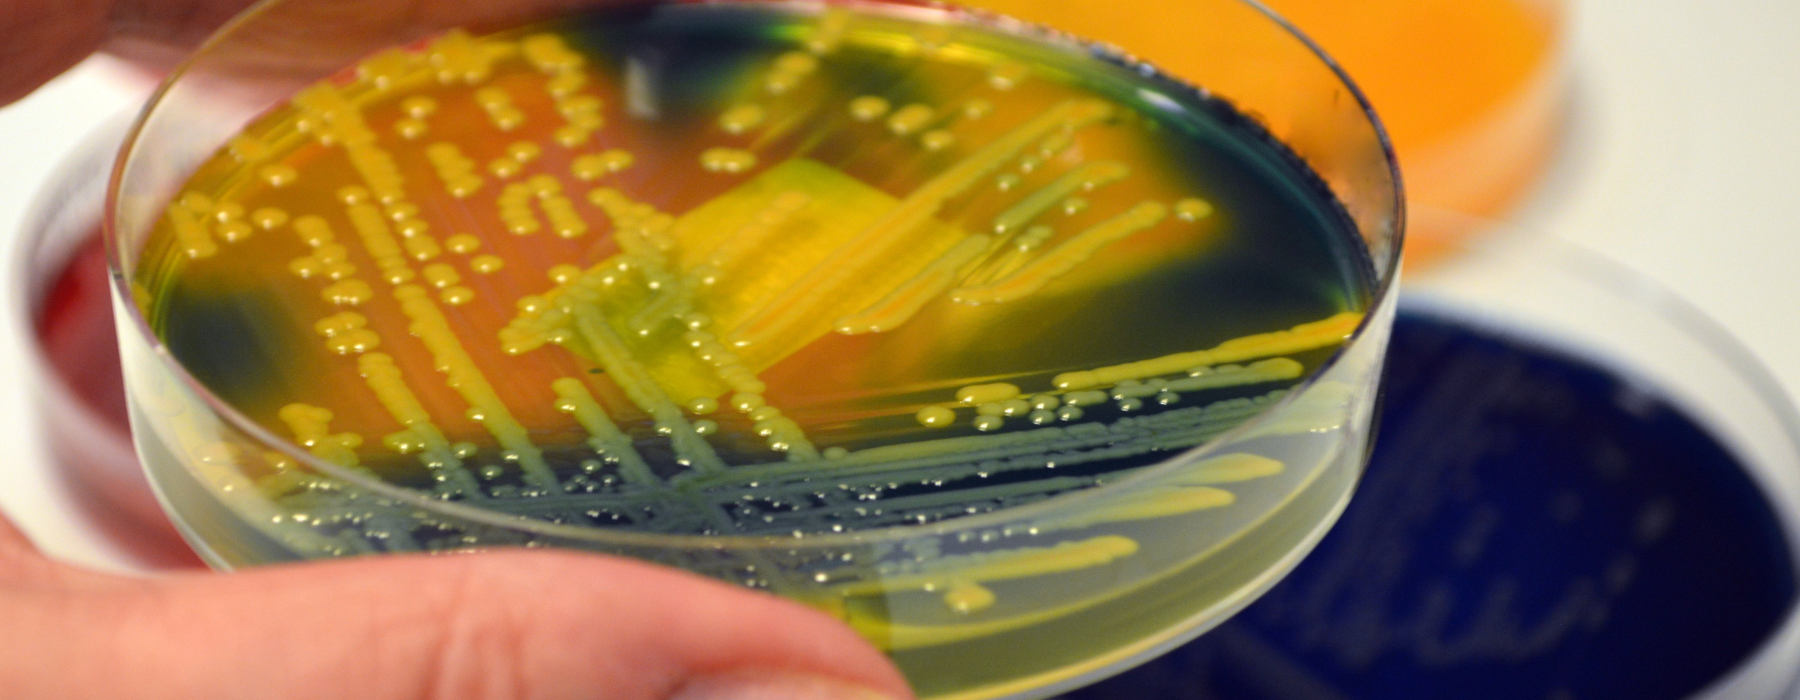

-
Antibióticos em idosos: cuidados e considerações importantes

O uso de antibióticos é muito importante no tratamento de infecções bacterianas, mas em idosos, esses medicamentos exigem cuidados redobrados. Com o envelhecimento, o corpo sofre várias mudanças fisiológicas que afetam a forma como os medicamentos são processados e metabolizados. Por isso, o uso de antibióticos em idosos deve ser cuidadosamente monitorado para evitar efeitos…
-
Superfungo Candida auris: quais são os perigos?

Quatro casos de infecção pelo superfungo Candida auris já foram confirmados no Brasil, mais precisamente em Belo Horizonte, no Hospital João XXIII. Dois pacientes já tiveram alta, um segue internado e o último veio a óbito. Mas é importante ressaltar que a morte nada tem a ver com o vírus, mas sim como consequência dos…
-
Pneumonia em idosos: sintomas, diagnóstico e tratamento

Boa parte dos casos de pneumonia são detectados nos idosos, ou seja, pessoas com mais de 60 anos. Isso ocorre porque esse é um grupo considerado de risco, estando mais suscetível a algumas doenças, inclusive as respiratórias. Por isso, é muito importante compreender como a pneumonia em idosos surge, como é feito o diagnóstico e…
-
Superbactéria no Brasil: o que é e como tratar?
Nas últimas semanas uma superbactéria foi identificada no Brasil, se tornando resistente a 15 antibióticos diferentes. Ela foi encontrada em uma mulher de 86 anos, diagnosticada com uma infecção urinária no ano de 2022. Apenas 24 horas após a internação, a paciente não resistiu e faleceu. Pesquisadores da USP estudaram a bactéria isolada na…
-
Febre Oropouche: o que é e como diagnosticar

Desde o começo deste ano, mais de 800 casos da Febre Oropouche foram confirmados no estado da Bahia. No Brasil, são mais de 7 mil até o momento. Mas afinal, o que é essa doença e como ela é transmitida? Neste artigo, daremos mais detalhes sobre o assunto, falando também sobre a relação da…
-
Doenças respiratórias: prevenção, sintomas e tratamentos

As doenças respiratórias formam um grupo diverso de condições que comprometem o sistema respiratório, como pulmões, vias aéreas e estruturas ligadas à respiração. Elas variam de leves a graves e podem impactar diretamente a saúde e a qualidade de vida. Por isso, entender suas causas, sintomas, formas de prevenção e tratamentos disponíveis é fundamental para…
-
Vírus Mayaro: o que é?

Os vírus emergentes são um constante desafio para a saúde pública global, e o vírus Mayaro não é exceção. Um estudo realizado pela Unicamp identificou a presença do vírus Mayaro entre humanos no estado de Roraima. Amostras de soro de pacientes com sintomas febris, coletadas entre 2020 e 2021 pelo Laboratório Central de Saúde…
-
Leptospirose: como se proteger durante as chuvas

A leptospirose é uma doença infecciosa causada pela bactéria Leptospira interrogans. Ela é transmitida através do contato com água ou solo contaminados com urina de animais infectados, especialmente ratos. Com o início do ano e final do verão, as chuvas e enchentes são comuns neste período e alguns cuidados precisam ser tomados para evitar…
-
Febre Maculosa: sintomas, diagnóstico e tratamento

A febre maculosa, também conhecida como febre do carrapato, é uma doença infecciosa causada pela bactéria Rickettsia rickettsii, transmitida aos seres humanos por meio da picada de carrapatos infectados. Os carrapatos vetores mais comuns são o Amblyomma americanum nos Estados Unidos e o Amblyomma cajennense no Brasil. Os casos de Febre Maculosa têm…
-
Bronquiolite em bebês

A bronquiolite, uma infecção respiratória que predominantemente afeta os bebês e crianças pequenas, é um problema de saúde infantil significativo. Este artigo busca fornecer um entendimento abrangente dos sintomas, tratamentos e potenciais complicações da bronquiolite, inclusive a sua relação com outros problemas respiratórios como a asma. O que é Bronquiolite? A Bronquiolite é uma infecção…
-
Doença de Addison

A doença de Addison, também conhecida como insuficiência adrenal primária, é uma condição rara, mas potencialmente séria. Este artigo explora o que é a doença de Addison, seus sintomas e como ela é tratada. O que é a Doença de Addison? A doença de Addison ocorre quando as glândulas adrenais, localizadas acima de cada…
-
O que é Afasia? Uma visão geral sobre a perda de linguagem

Foi relatado recentemente que o ator Bruce Willis foi diagnosticado com afasia. Embora possa não ser tão conhecida como outras condições médicas, a afasia é uma condição neurológica que afeta a habilidade de uma pessoa para compreender e usar a linguagem. Neste artigo, discutiremos o que é a afasia e como ela pode afetar a…